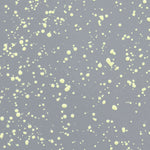

Značky

Hem
bez DPH: 9 463 Kč
White
Stolička Last
11 450 Kč
Dodání: 6-8 týdnů
Stolička je jedním z našich nejoblíbenějších a nejtrvalejších produktů. Designér Max Lamb ji vyrobil z jediného plechu, díky čemuž je neuvěřitelně pevná, a každá z nich má široký důlek pro snadné zvedání a přemisťování. Stolička je určena k sezení - hodí se ke každému typu stolu a do každého typu interiéru - ale zvažte ji i jako pohledný příležitostný stolek. Vyberte si mezi krásnou mědí nebo mosazí, jejichž povrch bude časem elegantně patinovat; jednobarevným smaltem pro okamžitý chromatický punc; nebo ručně stříkaným smaltem, kdy je každá stolička jedinečná.
Produkt je dostupný i v jiných variantách provedení. Pro více informací nás kontaktujte na space@arkhe.cz nebo navštivte náš showroom.
Barva
Poptejte produkt - Stolička Last
Rozměry
- Délka: 32 cm
- Šírka: 32 cm
- Výška: 44 cm
Informace
Materiál: plech
Informace o dodání
6-8 týdnů
Sdílet